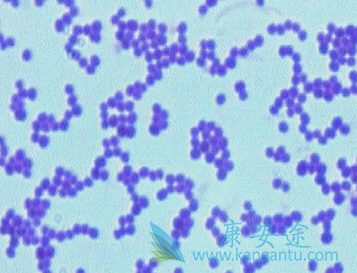
利奈唑胺 利奈唑胺

以下情况是利奈唑胺的相对禁忌证,需谨慎使用:(1)利奈唑胺有会有可能引起骨髓抑制的风险,如果有潜在的骨髓抑制性病变,如造血系统疾病、肿瘤化疗后,或明显的白细胞和血小板减少,或中重度贫血;
(2)利奈唑胺可引起视神经炎,患者如果存在视力损害、视物模糊、视野缺损等情况,需经眼科专家评估后方可使用;(3)利奈唑胺尚未在妊娠妇女中进行充分的、严格对照的临床研究,只有潜在的益处超过对胎儿的潜在风险时,才考虑在妊娠妇女应用。利奈唑胺是否分泌至人类的乳汁中尚不明确,因此,利奈唑胺应慎用于哺乳期妇女;
(4)利奈唑胺(斯沃)可能会引起血压升高的风险,高血压还没有控制的患者要谨慎的使用,若需使用必须进行血压监测;(5)利奈唑胺尚未用于嗜铬细胞瘤、类癌综合征和未经治疗的甲状腺机能亢进患者,因此,这些患者需慎用;(6)利奈唑胺有引起惊厥的报道,有癫痫发作病史的患者需慎用。
详情请访问 肿瘤 https://www.kangantu.com/
















请简单描述您的疾病情况,我们会有专业的医学博士免费为您解答问题(24小时内进行电话回访)